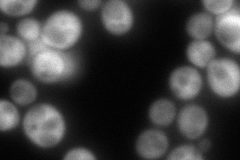
YDR158W

View description
Aspartic beta semi-aldehyde dehydrogenase, catalyzes the second step in the common pathway for methionine and threonine biosynthesis; expression regulated by Gcn4p and the general control of amino acid synthesis
Localization:
Intensity:
Fold change:
Significance:
-
C’ GFP library in SD

cytosol180.38 -
N' NOP1pr-GFP in SD

cytosol354.623 -
N' TEF2pr-mCherry in SD

cytosol395.316 -
N' NATIVEpr-GFP in SD
cytosol266.913 -
N' TEF2pr-VC and Cyto-VN in SD

#N/A0 -
C’ GFP library in SD+DTT

cytosol135.80.75No -
C’ GFP library in SD+H2O2

cytosol220.661.22No -
C’ GFP library in Starvation Media

cytosol277.471.53Yes -
C’ GFP library on the background of Pup2-DaMP

cytosol -
C’ GFP library on the background of CCT mutant

cytosol194.6071.07886No
